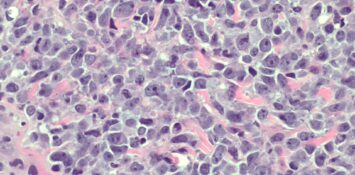

Коллоидный рак молочной железы
Коллоидный рак молочной железы (другие названия – муцинозный, слизистый) – это онкозаболевание, при котором развитие опухоли в груди сопровождается образованием большого количества слизи в межклеточном пространстве. Прогноз при этом виде рака – относительно благоприятный, он не склонен к метастазированию. Причины возникновения коллоидного рака молочной железы Здоровые клетки молочной железы – как протоков, так и долек, […]
Читать далее